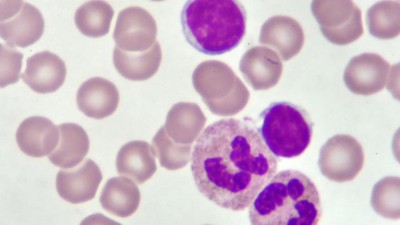

Neues Aus Der Cll-forschung
Neues aus der cll-forschung. Barbara Eichhorst Köln 0000. In unserem Nachrichtenticker können Sie live die neuesten Eilmeldungen auf Deutsch von Portalen Zeitungen Magazinen und Blogs lesen sowie nach älteren Meldungen suchen. Moderne Verfahren geben nun Hoffnung für viele Patienten über 65 Jahre.
Klar dachte ich wie zynisch es doch manchmal im Leben zugeht. Studien am Comprehensive Cancer Center der MedUni Wien und des AKH Wien zeigen dass die Wirkstoffe Ibrutinib und Idelalisib die in der zielgerichteten Therapie bei chronisch lymphatischer Leukämie eingesetzt werden das Überleben von HochrisikopatientInnen. Weiterhin spricht die Expertin über möglicherweise.
Eichhorst erklärt den Patienten die Wirkweise dieser alleinigen Tablettentherapie und geht auf mögliche Vorteile dieser Substanz ein. Das Team brütete CLL-Zellen mit bis zu 10 μM von ABT 737 alleine aus und beurteilte die Zellen als hochempfindlich für den Wirkstoff. 04072019 Die Chronische Lymphatische Leukämie kurz CLL ist die in unseren Breitengraden am häufigsten vorkommende Blutkrebsart.
Anfang 2014 erhielt er die Diagnose chronisch lymphatische Leukämie CLL eine Form von Blutkrebs. Die Apoptose trat innerhalb von 6 Stunden auf und die meisten Zellen unterlagen der Apoptose bei Dosen zwischen 10 NM und 100 NM. Die Behandlungsmöglichkeiten der Erkrankung haben sich in den vergangenen Jahren stark verbessert.
Die Expertin Prof. Für die Behandlung der chronisch lymphatischen Leukämie CLL wird es bald eine neue Therapieoption für Patienten mit wiederkehrender Erkrankung geben. Neuigkeiten aus der CLL-Forschung Vom 21072010 1934 Von Jan Geissler Drucken Ein folgende Bericht von Andrew Schorr des Health Talk Education Networks gibt neue Erkenntnisse eines Treffens von Mitgliedern des Chronic Lymphocytic Leukemia Research Consortium der wichtigsten US-amerikanischen CLL-Forschungsgruppe wieder.
Ich hatte ja eine halbe Ewigkeit in der medizinischen Diagnostik mit derartigen Krankheiten zu tun. Die deutsche CLL-Studiengruppe bewies in ihrer multizentrischen klinischen Studie der Phase II dass es möglich ist mit einer Stammzell-Transplantation auch ältere Patienten zu. Schockstarre Wut kein Boden mehr unter den Füßen.
Juli 2021 gestern und dieser Woche. Unser Newsticker zum Thema CLL enthält aktuelle Nachrichten von heute Freitag dem 2.
Barbara Eichhorst Köln gibt im Interview Antworten und stellt eine neue Zulassung für eine Kombination aus zwei Wirkstoffen Obinutuzumab plus Venetoclax bei der CLL-Therapie vor.
Weil sie oft gar nicht erst entdeckt werden sind diese Zellen sehr resistent gegenüber Angriffen des Immunsystems. Das Team brütete CLL-Zellen mit bis zu 10 μM von ABT 737 alleine aus und beurteilte die Zellen als hochempfindlich für den Wirkstoff. In unserem Nachrichtenticker können Sie live die neuesten Eilmeldungen auf Deutsch von Portalen Zeitungen Magazinen und Blogs lesen sowie nach älteren Meldungen suchen. Eichhorst erklärt den Patienten die Wirkweise dieser alleinigen Tablettentherapie und geht auf mögliche Vorteile dieser Substanz ein. Neue Therapie bei chronisch lymphatischer Leukämie könnte Chemotherapie ersetzen. Die Apoptose trat innerhalb von 6 Stunden auf und die meisten Zellen unterlagen der Apoptose bei Dosen zwischen 10 NM und 100 NM. 04072019 Die Chronische Lymphatische Leukämie kurz CLL ist die in unseren Breitengraden am häufigsten vorkommende Blutkrebsart. Neuigkeiten aus der CLL-Forschung Vom 21072010 1934 Von Jan Geissler Drucken Ein folgende Bericht von Andrew Schorr des Health Talk Education Networks gibt neue Erkenntnisse eines Treffens von Mitgliedern des Chronic Lymphocytic Leukemia Research Consortium der wichtigsten US-amerikanischen CLL-Forschungsgruppe wieder. Weiterhin spricht die Expertin über möglicherweise.
Schockstarre Wut kein Boden mehr unter den Füßen. 04072019 Die Chronische Lymphatische Leukämie kurz CLL ist die in unseren Breitengraden am häufigsten vorkommende Blutkrebsart. Studien am Comprehensive Cancer Center der MedUni Wien und des AKH Wien zeigen dass die Wirkstoffe Ibrutinib und Idelalisib die in der zielgerichteten Therapie bei chronisch lymphatischer Leukämie eingesetzt werden das Überleben von HochrisikopatientInnen. Ich hatte ja eine halbe Ewigkeit in der medizinischen Diagnostik mit derartigen Krankheiten zu tun. Schockstarre Wut kein Boden mehr unter den Füßen. Die Apoptose trat innerhalb von 6 Stunden auf und die meisten Zellen unterlagen der Apoptose bei Dosen zwischen 10 NM und 100 NM. In unserem Nachrichtenticker können Sie live die neuesten Eilmeldungen auf Deutsch von Portalen Zeitungen Magazinen und Blogs lesen sowie nach älteren Meldungen suchen.

Post a Comment for "Neues Aus Der Cll-forschung"